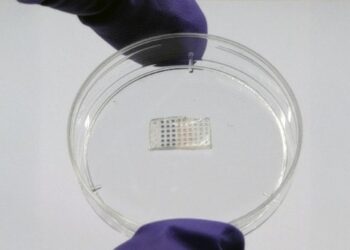

집단사직 석달 넘어가면서 일부 전공의 ‘생활고’ 호소
장기 사직으로 생활고를 겪는 전공의들에게 선배 의사들이 매달 25만원을 무이자나 저금리로 빌려준다.
28일 의료계에 따르면 대한의사협회(의협)는 선배 의사가 매달 전공의 1명에게 25만원을 무이자나 2% 이하의 저금리로 대출해주는 ‘선배 의사와의 매칭 지원사업’을 추진하고 있다.
의협은 지난 23일부터 구글 폼을 통해 후원을 원하는 선배 의사와 전공의들의 사업 참여 신청을 받고 있으며, 추후 매칭을 통해 전공의들을 지원한다는 방침이다.
후원자는 대출 가능 금액과 매달 후원 가능 여부 등을 기재해야 한다. 의협이 대출금을 지급보증하지는 않는다.
후원을 원하는 전공의는 대출하고자 하는 금액과 상환 계획 등을 구체적으로 밝혀야 한다.
전공의 사직이 석 달 넘게 이어지자 의협은 이달 2일부터 온라인과 ‘전공의 지원 전용 콜센터'(1566-2844)를 통해 1인당 1회 100만원을 지급하는 긴급생계지원금 신청도 받고 있다.
의협에 따르면 지난 21일 기준 전공의 1천646명이 생계지원금 지급을 신청했다.
이외에도 의협은 보건의료정책 개선책을 듣는 ‘전공의 대상 수기 공모 사업’을 진행해 선정된 전공의들에게 50만원의 상금을 지급하겠다고 밝혔다.
전공의들이 정부의 의대 증원 추진에 반발해 의료 현장을 떠난 지 석 달이 넘어가면서 ‘생활고’를 호소하는 이들이 늘어나고 있다.
한 사직 전공의는 “경제적 어려움을 겪는 사람들은 지인을 통해서 의사 직군이 아닌 일을 구한다”며 “과외나 병원 행정직, 배송 알바 등을 하는 친구들이 있다”고 전했다.